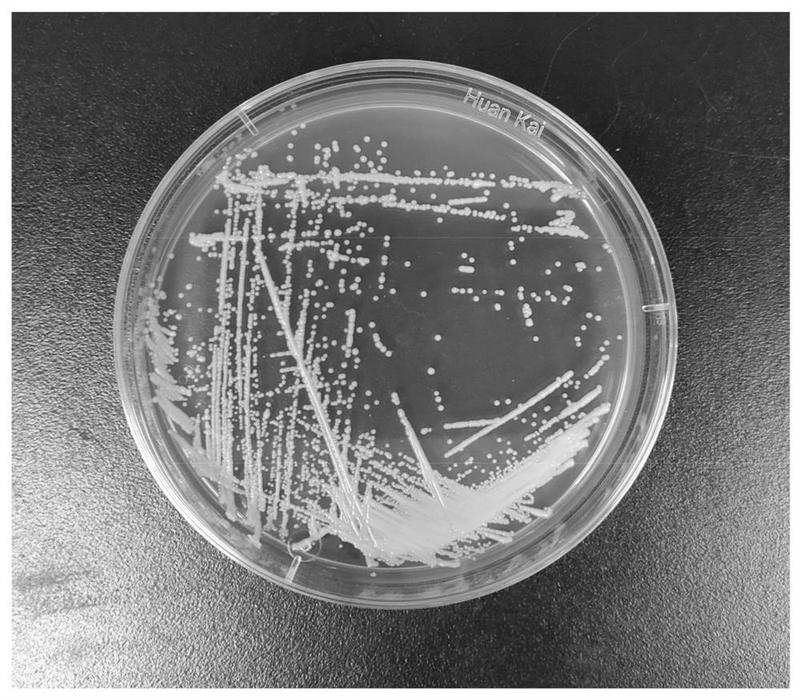
并能显著提高酱油或酱中462乙基愈创木酚,谷氨酸和/或β62苯乙醇

β苯乙醇

β,β-二氟甲基4-苯乙醇
图片尺寸250x250
gbw(e)082065在售 β-苯乙醇乙醇水溶液标准物质
图片尺寸1000x1595
β-亚甲基苯乙醇结构式
图片尺寸605x375
2-苯乙醇 - 上海阿拉丁生化科技股份有限公司 - 阿拉丁
图片尺寸300x300
β-苯乙醇 工业级 苯乙醇 有机合成 多聚化学
图片尺寸750x750
常温下为白色针状结晶,可燃,易溶于热水,甲醇,乙醇,乙醚,丙酮,苯,难溶
图片尺寸1280x1280
α-苯乙醇
图片尺寸142x128
β苯乙醇
图片尺寸300x300
***d100溶剂油
图片尺寸2048x1536
2-氨基苯乙醇
图片尺寸726x369
【dmso和乙醇】 - 分析测试百科网
图片尺寸188x188
高纯度β-苯乙醇香精 调酒用香料食品添加香精高档酒专用品食品级
图片尺寸800x800
β苯乙醇
图片尺寸644x311
苯乙醇
图片尺寸1080x1080
β-苯乙醇合成工艺的研究 第 1 页
图片尺寸904x1262
s-(-)-1-苯乙醇
图片尺寸255x227
对羟基苯乙醇; 4-羟基苯乙醇
图片尺寸400x400
(r)-( )-4-甲基苯乙醇腈
图片尺寸720x450
并能显著提高酱油或酱中462乙基愈创木酚,谷氨酸和/或β62苯乙醇
图片尺寸800x700
苯乙醇
图片尺寸800x358
















082065_20130701_160425979_697221.JPG)